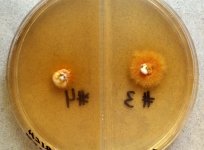

<< back to search
IMAGES:


Search Details
add to cart
| UAMH Number: | 10323 |
|---|---|
| Species Name: | Trichophyton soudanense |
| Type: | |
| Synonyms: | Achorion soudanense / Achorion violaceum / Achorion yaoundei / Arthrosporia violacea / Bodinia glabra / Bodinia violacea / Endotrichophyton violaceum / Favotrichophyton glabrum / Favotrichophyton violaceum / Langeronia soudanensis / Sabouraudites violaceus / Trichophyton glabrum / Trichophyton gourvilii var. gourvilii / Trichophyton pterygoides var. violaceum / Trichophyton violaceum var. indicum / Trichophyton violaceum var. violaceum / Trichophyton yaoundei |
| Taxonomy: | FUNGI Ascomycota, Eurotiomycetes, Onygenales, Arthrodermataceae |
| Strain History: | Kinahan, C. (89052186) -> UAMH |
| Substrate: | scalp, female 11 yr, originally from Africa | Location: | CANADA Saskatchewan, Saskatoon (GEO: 52.133,-106.67) |
| Isolator: | C. Kinahan |
| Isolation Date: | 2016-03-03 |
| Date Received: | 2003-07-08 |
| Characters: | CULTURE CONDITIONS BCP-MS-G slow growth, alkalinity, hydrolysis; urea negative - // CULTURE CONDITIONS produces macroconidia on PYE at 30C - // CULTURE CONDITIONS stimulated by thiamine - // PIGMENT tan on PDA; yellow on PYE - (Click for publications citing UAMH 10323) |
| Compounds: | |
| Cross Reference: | |
| Collections: | Living Strains; Dried Herbarium Material |
| Pathogenic Potential: | Human: yes | Animal: yes | Plant: no |
| Biosafety Risk Group: | RG2 (check the PHAC ePATHogen Risk Group Database for updates) |
| Regulatory Requirements: | Canadian requesters must provide PHAC Pathogen and Toxin License Number (see: https://www.canada.ca/en/public-health/services/laboratory-biosafety-biosecurity/licensing-program.html) prior to shipment. International requesters must provide all legally required importation documentation prior to shipment. Plant pathogenicity status may be verified by using the USDA Agricultural Research Service (ARS) Fungal Database |
| MycoBank ID: | 119520 |
IMAGES: